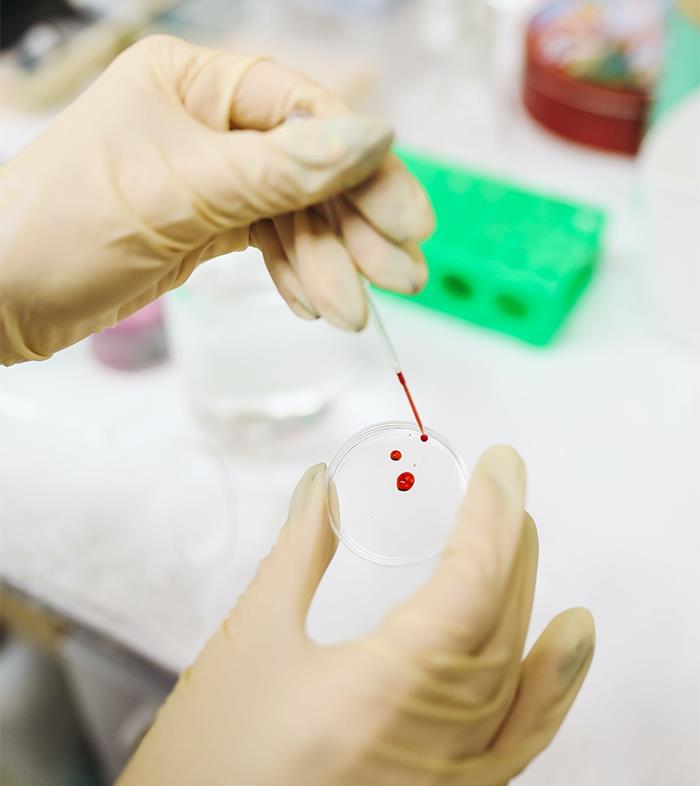
“What Is A Fact About The Human Body That Not Many People Know About?” (50 Answers) “What Is A Fact About The Human Body That Not Many People Know About?” (50 Answers)

The human body is everything that makes up, well, us. However, there are plenty of fascinating things we don’t know about it, or rather, ourselves.
Once you look closer, dive under the surface of the skin, explore the inner workings of the biological systems that ensure our everyday life, you just can’t help but admire the marvel that you really are.
To learn more about our bits and pieces, Redditor u/Zenssei made a post on r/AskReddit, asking other platform users to share some facts about the human body that not many people know about. Their call to action was immediately answered.
u/Zenssei said the idea for this post came to them pretty naturally. “I was just watching TV, thinking of [something] I could post on r/AskReddit,” they told Bored Panda.
“I have learned quite a bit from the comments such as there is a right and a wrong way to swallow, or that about 20% of people have a bone ridge on the roof of the mouth… It was fun reading through the replies.”
As of this article, the post already has received over 56K upvotes and 23K comments, and has become one of the coolest online trivia archives out there!
#1
Your brain regulates how strong your muscles are. If your leg muscles were to contract at full strength, they would snap your femur.
Its why people in emergencies on adrenaline can lift cars off children. Your body is capable of great strength, but it could also severely damage you, so your brain keeps you a weak, soft bag of jelly.

Image source: Andibular, unsplash
#2
When doing surgery where the doctors have to take out some organs, when placing them back, they don’t have to be put back In the exact position there meant to be, your body kind of just, moves the organs into the correct position after the surgery

Image source: IamaJarJar, pexels
#3
People who live in “extreme” conditions for generations adapt in extreme ways. For example people that live in high elevations often have larger lungs and different blood makeup. Or my favorite is the Bajau people that live on the water and spend a lot of their time diving, their spleens have become 50% larger in order to store more blood.

Image source: localhelic0pter7, flickr
#4
You hate the sound of your recorded voice because it’s missing the low frequency you’re used to hearing.
When you talk, you hear your voice as it goes to the air and back to you ear. It also goes through your skull to your ear, and this bone conduction mechanism transmits the low frequencies better than air does.
Your recorded voice only has the air transmitted sound. That causes the dissonance between what you think your voice sounds like, and what it really does. It’s also why your voice will (almost) always be higher pitch than you think.

Image source: BlocterDocterFocter, unsplash
#5
The heart smells like mushrooms.
Source: I’m a cardiac anesthesiologist

Image source: littlepoot, unsplash
#6
Humans have, on average, just as many hairs on their body as chimpanzees, human hair is just a lot shorter and finer.

Image source: Inner_Inspection6408, pexels
#7
Your eyes have a separate immune system from the rest of your body and in a lot of occasions if your body’s immune system finds your eyes, they will assume they are a foreign body and blind you.

Image source: SlavicSquat1234, pexels
#8
Humans are bioluminescent and glow in the dark, but the light that we emit is 1,000 times weaker than our human eyes are able to pick up.

Image source: -eDgAR- , unsplash
#9
When you cry and your nose becomes runny, it’s actually your tears.

Image source: Bitchmom_6969, pexels
#10
The reason it’s so easy to break your collar bone is because its designed to break.
The way it was explained to me is that its like a circuit breaker. It breaks there to stop the shock of impact getting to your spine

Image source: Hardboiledsoftshell, wikimedia
#11
Our brains make up, on average, around 2% of our body weight but consume 20% of our caloric intake

Image source: MoodyTeeth, pexels
#12
Your body will reduce your muscle strength to protect your spine.
Stand on flat ground, hold your arms out in a t-pose, and have a friend push down on your hand while you try to hold it in place. That’s your control, how strong you actually are.
Now, remove 1 shoe (or put a book under 1 foot) and repeat with your hips askew so your spine isn’t straight. An inch is all it takes.
Your strength will be reduced to the point that your friend can use a single finger to push your hand down.
Image source: MyNameIsRay
#13
Alzheimer’s disease isn’t just gradual loss of memory. It physically exists in the brain. It’s a physical substance that attacks the brain. Like, if you were able to open the skull of a person suffering from Alzheimer’s disease to take a look at their brain, you would actually see this sticky, fibrous, grey physical matter overtaking their brain.
Image source: cccairooo
#14
The eyeball is the fastest healing part on your body.

Image source: _Nugget_UwU, unsplash
#15
You will sooner die from lack of sleep than lack of food.
You can live, depending on your current body fat and health level, for months without food. Estimates are you that you will die for lack of sleep within 2 weeks

Image source: feliciates, unsplash
#16
The appendix is not a vestigial organ. It actually protects good bacteria in the gut. You can live without it, but it’s not just chillin’ in there
Image source: S_J_Emerald
#17
Scars are not made of “permanent” tissue (they’re held together by collagen) and are in a constant state of repair. This repair is facilitated by vitamin C (amongst other things). Yes, this means that people with scurvy (from vitamin C deficiency) will see all their old scars reopen into fresh wounds.
Image source: misterway
#18
Some women can feel the exact moment an egg is released from the ovary during ovulation. Feels like a little pop just on one side. Pretty neat

Image source: blueridge97, unsplash
#19
Humans are one of a few species of mammal that oddly don’t produce their own vitamin C due to lack of a certain enzyme. Other mammalian species who exhibit this mutation are those contained in the main primate suborder Haplorhinni (monkeys, apes, tarsiers), as well as bats, capybaras, and guinea pigs.
All other mammals produce vitamin C in the liver.

Image source: TexasPatrick, unsplash
#20
You can calm yourself down by splashing cold water on your face to trigger the mammalian diving reflex.
Image source: Cruithne
#21
You can grow a new human being faster than most missing toenails can grow back

Image source: CurrentAttention3, unsplash
#22
If you carry a lot of unprocessed trauma, it can cause psychosomatic autoimmune diseases.
Image source: andyroybal
#23
X-rays of childrens mouths are nightmare fuel. The second set of teeth to replace baby teeth are already grown and lodged in their skulls. So you’ll see two rows of teeth and its freaky looking. They don’t grow in when the old ones fall out, they are already loaded in the chamber waiting to get launched.

Image source: demonardvark, pexels
#24
The surface area of the lungs is about the same size as a tennis court

Image source: felipebsr, unsplash
#25
If you say haaah your breath comes out warm,but when you say Woooh it comes out cold.
Image source: Marianmza
#26
It’s possible to pull a jaw muscle while yawning. I found this out the hard way at work one day.

Image source: MissSara101, unsplash
#27
Your body must warm fluids before absorbing them, so drinking ice cold water to hydrate is only burning more energy, and you’re not hydrating as quickly.
Image source: Cordero_Biggs
#28
That there is NOT 20 lbs of toxic poop in your body at any given time. But apparently a ton of people still believe all sorts of ads about some pill or another being able to flush some imaginary “toxins” out of your body like it’s going to magically cure you of 20 years of terrible eating and exercise habits.
Image source: SolarisIX
#29
Apparently not everyone knows that women grow a new organ while pregnant.
In addition to growing a child, they grow the placenta.
Image source: HeartKevinRose
#30
39% of people have an extra bone in their knee. 100 years ago only 11% of people had this bone.

Image source: Cruithne, flickr
#31
Your brain continues to try to revive the body long after the heart has stopped. In some cases 30 hours later there has been found brain activity trying to make repairs to bring the body back. This is used to indicate time of death in murder victims.

Image source: flamingphoenix9834, unsplash
#32
The proportion of your vision that is actually in sharp focus roughly equates to the size of your thumbnail at arm’s length. The rest of it is just your visual cortex filling in the blanks.
Image source: misterway
#33
In children under 11 (for some reason), cutting off the fingertip from the last knuckle will result in complete regeneration of the finger in 100% of cases, assuming the naibed is intact. There’s no explanation for why this happens, why it only happens to children under 11 and why it can’t be sequences to fully regenerate / grow organs. It also occurs in many animals, as observed in test rodents.
I learned that in science class in grade 8 and my dad called me a liar. I showed him my science textbook and he threw it away and said it was fake.
Image source: josiahpapaya
#34
You can live “normally” with half your brain. In some severe drug resistant epileptic syndrom in young kids, the only option to stop the seizures is to remove a complete brain hemisphere.
After a while, with proper reeducation and all, the children can go on to have a normal life without cognitive deficit. They will have a limping, blindness from one eye and a very weark arm but can lead a normal life and not end up cognitively impaired.
One of the earliest sign of alzheimer’s disease, before the memory loss, could be the loss of the sense of smell. It’s also the case with Parkinson disease.
Our brain looks wrinkled because it is actually “folded” inside our skull in order to fit a maximum of surface and thus neurons & cell communications. Some animals like rodents have a completely smooth brain.

Image source: Matrozi, unsplash
#35
Every minute you shed over 30,000 dead skin cells off your body

#36
The reason it feels weird when you or someone touches the inside of your belly button is because the nerves actually go to your spinal cord. These nerves lie at the same level that relay signals to your urethra and bladder. So when you feel like you have to pee when you touch the inside of your belly button, that’s why.
Image source: purgingitall
#37
You can poop out of your mouth if your intestines get backed up enough. It’s like vomit, doesn’t look like actual poop per se, but it’s still disgusting.

Image source: DTownForever, unsplash
#38
Humans have stripes, we just normally can’t see them. They’re called Blaschko’s lines and form along the paths of embryonic cell migration. The stripes are sort of U-shaped down our front, V-shaped on our back, wavy on the head and face and we have basic, simple stripes on our extremities.

Image source: LadySygerrik, pexels
#39
Each one of your eyes has a blind spot where the optic nerve exit your eye into your brain. You can’t see it because your brain tricks you not to see, it covers the spot with some made up image of what it thinks fits better with the rest of it.
Image source: Windshards2
#40
We’re the best marathon runners in the animal kingdom and can win a marathon against any animal out there.
Image source: Keinichn
#41
The average adult has 22 square feet of skin. Perfect size for a nice rug.

Image source: angry_centipede, pexels
#42
Human eggs are small but big enough to be visible to the human eye

Image source: Truly_Meaningless, unsplash
#43
Baby don’t get knee caps until 2-6 years old
Image source: Additional_Ad4880
#44
Your brain likes stimulation, if it doesn’t get any it will make some up, some people are more sucepticle to it then others, the colors you see before you fall asleep are a common mild occurrence, there are several classes of these hallucinations, closed-eye visuals, which are caused by leaving your eyes closed for a long time, hypnagogia, which is caused by the onset of sleep, prisoners cinema, which is caused by looking into a dark place for a long time, ganzfeld effect, which is caused by blocking out all external stimuli, and Charles bonnet syndrome, caused by sight loss.
Most are these are simple phosphenes but some can be whole imagined scenes, or more abstract fractal-like imagery
Image source: NoCommunication7
#45
When you have a bowel movement, your heart rhythm shifts temporarily due to a vagus response. The reason Elvis died on the toilet was because his heart was beating 200+ bpm and the quick rhythm change caused a myocardial infarction. People with low heart rates have been known to pass out on the toilet because their bodies can’t handle the shift.
It’s also why EMTs will absolutely not let you use the bathroom before getting on the ambulance. Especially if the bathroom is a standard 5’x8′.
Image source: MadameBurner
#46
Jaw muscles are the strongest in the human body

Image source: Exciting_Clock2807, unsplash
#47
It only takes about 15 pounds of force to rip off a human ear

Image source: 02K30C1 , pexels
#48
Synovial joint fluid is the most frictionless stuff on the planet (unless they’ve synthetic’ed something up that recently.)

Image source: that_doesnt_gothere, unsplash
#49
30% of body waste is excreted via skin
Image source: insomniac_observer
#50
If you faint at the sight of your own blood you may have an oversensitive vasovagal response. The theory is that this developed as a survival mechanism, kind of like an opposum playing dead.
Follow Us





